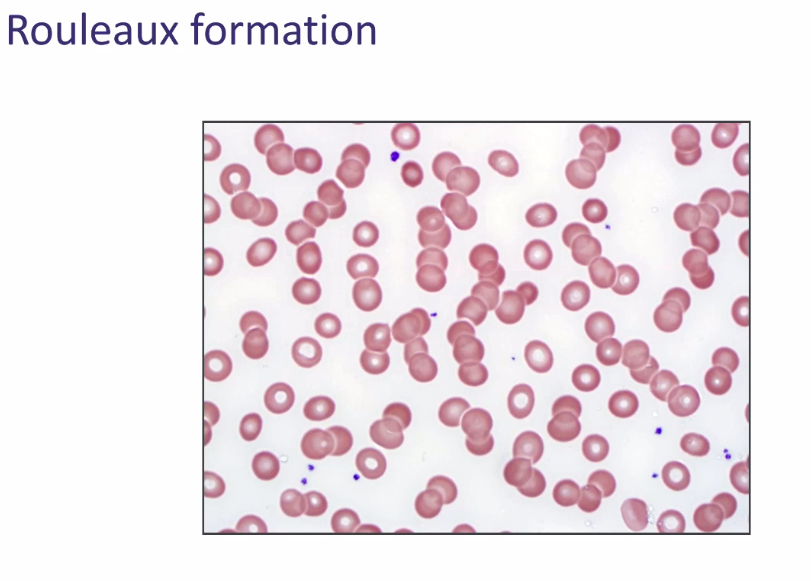

What is the therapy for myeloma?
High dose combination therapy with autologous stem cell transplant
What is the significance of Ig light chains in multiple myeloma?
Myeloma cells produce more light chain than heavy chain
-> extra light chains floating around
What is the normal kappa:lamba ratio in plasma cells?
What is the significance of a deviation from this ratio?
Kappa:Lambda = 2:1
Deviation => Clonal population (possible malignancy, cannot diagnosis without consistent clinical features)
What hematologic malignancy arises from plasma cells?
Multiple myeloma
What cytokine drives myeloma cell growth, survival, and Ig production?
IL-6
What is the most frequent cause of death in multiple myeloma?
Infection
Malignant plasma cells
What testing method do we use to find monoclonal gammopathies?
SPEP or UPEP

What are the characteristics of plasma cells?
(2 morphologic features, 2 markers)
Markers are cytoplasmic => detected on immunostain, not flow

What do plasma cells produce in abundance that can have pathologic effects on organs (especially the kidney)?
Immunoglobulins (antibodies) -> deposition -> tissue damage
Ig Light chains can also form amyloid -> tissue damage
What finding on peripheral blood smear may be concerning for multiple myeloma?
Roleaux formation (stack of coins)
What is the diagnosis if a patient has 10-60% monotypic plasma cells but no clinical sings of myeloma?
Smolering myeloma
75% chance of turning into myeloma
What will plasma cells look like on flow cytometry?
CD 19+
CD56-
If CD19- and CD56+, likely a neoplastic plasma cell
Immunostain will show CD138+, CD38+ (but cytoplasmic)
What are the diagnostic criteria for multiple myeloma?
≥ 10% clonal plasma cells in the bone marrow, in the setting of myeloma-defining clinical criteria
Monoclonal gammopathy is not sufficient to diagnose - need clinical criteria
What do Bence Jones protiens in the urine indicate?
Multiple myeloma
If consistent clinical picture (ex: lytic bone lesions, hypercalcemia)
Ig Light Chains enter the urine -> Bence Jones proteins
How does the presentation of Waldenstrom’s macroglobulinemia differ from that of myeloma?
Waldenstrom will have:
Waldenstrom is an IgM monoclonal gammopathy
List the clinical findings of myeloma (6)
How does multiple myeloma lead to bone destruction?
Myeloma cells produce factors that drive bone destruction